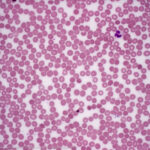

Beschreibung
Milzerkrankungen umfassen eine Reihe von Erkrankungen, die die Milz betreffen, ein wichtiges Organ, das sich im linken Oberbauch befindet. Diese Erkrankungen können sich auf verschiedene Weise äußern, wobei die Symptome von leichten Beschwerden bis hin zu schweren Komplikationen reichen können. Dazu gehören Hyposplenismus, Hypersplenismus, chronische kongestive Splenomegalie, Milzabszess, Milzzyste, Milzinfarkt und andere seltenere Erkrankungen. Zu den Symptomen können Müdigkeit, Bauchschmerzen, Fieber, Infektionen und Komplikationen im Zusammenhang mit Blutkörperchenmangel gehören.
Die Prävalenz von Milzerkrankungen variiert je nach ursächlichen Faktoren und Bevölkerungsstruktur. Obwohl diese Erkrankungen relativ selten sind, sind sie seit jeher bekannt und werden bereits in alten medizinischen Texten erwähnt. Die Fortschritte in der Medizin haben im Laufe der Zeit zu einem deutlich besseren Verständnis, einer besseren Diagnose und Behandlung von Milzerkrankungen geführt.
Unbehandelte Milzerkrankungen können zu schweren Komplikationen führen, vor allem aufgrund der erhöhten Anfälligkeit für Infektionen, die auf eine geschwächte Immunantwort zurückzuführen ist. Die Komplikationen können von lokalen Infektionen bis hin zu lebensbedrohlichen systemischen Infektionen reichen. Eine rechtzeitige Diagnose und Intervention sind entscheidend, um solche Komplikationen und ihre möglichen Folgen zu verhindern.
Die Diagnose von Milzerkrankungen umfasst eine umfassende klinische Untersuchung, einschließlich Anamnese und körperlicher Untersuchung. Labortests, wie z. B. ein großes Blutbild, spielen eine entscheidende Rolle bei der Bestätigung des Vorliegens und des Schweregrads dieser Erkrankungen. Die Behandlungsstrategien zielen darauf ab, sowohl die zugrunde liegenden Ursachen als auch die daraus resultierende Immunschwäche zu bekämpfen. Sofortmaßnahmen können die Absetzung von Medikamenten, die für medikamenteninduzierte Fälle verantwortlich sind, die Behandlung von Infektionen und die Verwendung von Wachstumsfaktoren zur Stimulierung der Produktion weißer Blutkörperchen umfassen. Bluttransfusionen können notwendig sein, um die Anzahl der weißen Blutkörperchen schnell wiederherzustellen.
Verschiedene Faktoren können zu Milzerkrankungen führen, darunter medikamenteninduzierte Fälle, die häufig mit Medikamenten in Verbindung stehen, die die Knochenmarkfunktion unterdrücken oder Autoimmunreaktionen auslösen. Infektionen, angeborene Erkrankungen, genetische Faktoren und zugrunde liegende Erkrankungen können ebenfalls zu diesen Erkrankungen beitragen.
Zur Vorbeugung von Milzerkrankungen gehört die medikamentöse Behandlung, insbesondere bei Medikamenten, von denen bekannt ist, dass sie diese Erkrankungen auslösen. Eine regelmäßige Überwachung des Blutbildes bei Risikopersonen und ein sofortiges Eingreifen bei Auffälligkeiten können dazu beitragen, eine schwere Immunschwäche zu verhindern.
Die Biologie dahinter
Die Milz, die sich unterhalb des Brustkorbs auf der linken Seite des Bauches befindet, spielt eine zentrale Rolle im hämatopoetischen System und in der Immunantwort des Körpers. Ihre normale Funktion umfasst ein komplexes Zusammenspiel von Funktionen, die zur allgemeinen Gesundheit beitragen.
Die Milz fungiert als wichtiges Blutfilterorgan, das für die Entfernung beschädigter oder alter roter Blutkörperchen, Blutplättchen und Zelltrümmer aus dem Blutkreislauf verantwortlich ist. Dieser Prozess gewährleistet die Aufrechterhaltung einer gesunden Blutzusammensetzung und die Beseitigung von Fremdpartikeln und Mikroorganismen, wodurch die Abwehrkräfte des Körpers gegen Infektionen gestärkt werden.
Darüber hinaus dient die Milz als Reservoir für rote Blutkörperchen und gibt diese in den Blutkreislauf ab, wenn der Körper eine erhöhte Sauerstofftransportkapazität benötigt, beispielsweise bei körperlicher Anstrengung oder als Reaktion auf Stress. Während die meisten weißen Blutkörperchen im Knochenmark produziert werden, spielt die Milz eine Rolle bei der Bildung einer bestimmten Untergruppe, die als Monozyten bekannt ist. Darüber hinaus beherbergt die Milz eine beträchtliche Anzahl von Immunzellen, darunter Lymphozyten und Makrophagen. Diese Immunzellen spielen eine wichtige Rolle bei der Identifizierung und Bekämpfung von Krankheitserregern wie Bakterien und Viren und tragen somit wesentlich zur Immunantwort des Körpers bei. Darüber hinaus ist die Milz an der Antikörperproduktion beteiligt und stärkt so die Wirksamkeit des Immunsystems bei der Abwehr von Infektionen.
Spleenerkrankungen stören jedoch diese komplexen Funktionen. Bei einer Hyposplenismus ist die Funktionsfähigkeit der Milz eingeschränkt, wodurch sie weniger effektiv Blut filtern und Krankheitserreger entfernen kann. Diese Funktionsminderung erhöht die Anfälligkeit für Infektionen, insbesondere solche, die durch gekapselte Bakterien verursacht werden, da die Milz diese Krankheitserreger nicht ausreichend aus dem Blutkreislauf entfernen kann.
Arten und Symptome
Milzerkrankungen umfassen eine Reihe von Erkrankungen, die die Struktur und Funktion der Milz beeinträchtigen. Das Verständnis der verschiedenen Arten von Milzerkrankungen ist für eine genaue Diagnose und maßgeschneiderte Behandlungsansätze von entscheidender Bedeutung.
Hyposplenismus:
Hyposplenismus bezeichnet einen Zustand verminderter Milzfunktion, der häufig auf zugrunde liegende Erkrankungen, die operative Entfernung der Milz (Splenektomie) oder angeborene Faktoren zurückzuführen ist. Häufige Symptome sind eine erhöhte Anfälligkeit für Infektionen, insbesondere solche, die durch gekapselte Bakterien wie Streptococcus pneumoniae verursacht werden. Patienten können unter wiederkehrenden Infektionen der Atemwege, Sinusitis und Lungenentzündung leiden. Darüber hinaus haben Menschen mit Hyposplenismus aufgrund ihrer beeinträchtigten Immunantwort möglicherweise ein höheres Risiko, eine schwere Sepsis zu entwickeln.
Hypersplenismus:
Im Gegensatz dazu ist der Hypersplenismus durch eine Überfunktion der Milz gekennzeichnet, die Blutkörperchen vorzeitig zerstört. Die Symptome des Hypersplenismus äußern sich in einer Verringerung der Anzahl der roten Blutkörperchen, der weißen Blutkörperchen und der Blutplättchen, was zu Anämie, erhöhter Anfälligkeit für Infektionen und einem erhöhten Blutungsrisiko führt. Die Patienten können unter Müdigkeit, Blässe, leichter Blutergussneigung und häufigen Nasenbluten leiden. Eine Vergrößerung der Milz (Splenomegalie) ist ein häufiges Merkmal des Hypersplenismus und kann zu Beschwerden oder Schmerzen im linken Oberbauch führen.
Chronische kongestive Splenomegalie:
Die chronische kongestive Splenomegalie ist durch eine anhaltende Vergrößerung der Milz aufgrund einer chronischen Stauung gekennzeichnet. Diese Erkrankung tritt häufig als Folge von zugrunde liegenden Herz- oder Lebererkrankungen auf, die den Blutfluss in der Pfortader beeinträchtigen. Zu den Symptomen können Bauchschmerzen, frühes Sättigungsgefühl und ein Völlegefühl im Oberbauch gehören. In schweren Fällen können Komplikationen wie portale Hypertonie und Varizen auftreten.
Milzabszess:
Ein Milzabszess ist eine lokale Ansammlung von Eiter in der Milz, die in der Regel durch eine bakterielle Infektion verursacht wird. Patienten mit dieser Erkrankung können Fieber, Schüttelfrost und Bauchschmerzen haben, die oft im linken oberen Quadranten lokalisiert sind. Milzabszesse können manchmal zu einer Sepsis oder einer Ruptur der Milz führen, einer lebensbedrohlichen Komplikation.
Milzzyste:
Milzzysten sind mit Flüssigkeit gefüllte Säcke, deren Größe variieren kann. Während viele Menschen mit Milzzysten symptomfrei bleiben, können größere Zysten Beschwerden oder ein Völlegefühl im Bauchraum verursachen. In seltenen Fällen können Zysten reißen, was zu plötzlichen und starken Bauchschmerzen führt.
Milzinfarkt:
Ein Milzinfarkt tritt auf, wenn der Blutfluss zu einem Teil der Milz unterbrochen ist, was zum Absterben von Gewebe führt. Zu den Symptomen kann akuter linksseitiger Bauchschmerz gehören, der anderen abdominalen Erkrankungen ähneln kann. Ein Milzinfarkt kann durch Grunderkrankungen wie Sichelzellenanämie, Gefäßerkrankungen oder Embolien aus anderen Körperteilen verursacht werden.
Andere Milzerkrankungen:
Diese Kategorie umfasst seltenere Milzerkrankungen, die sich auf verschiedene Weise manifestieren können. Dazu können gutartige Tumore, hämatologische Erkrankungen, die die Milz betreffen, oder Autoimmunerkrankungen gehören, die die Milz befallen. Die Symptome können vielfältig sein und reichen von asymptomatisch bis hin zu Bauchschmerzen, Anämie oder abnormalen Blutbildwerten.
Komplikationen:
Komplikationen von Milzerkrankungen können schwerwiegend und lebensbedrohlich sein. Bei Hyposplenismus ist die bedeutendste Komplikation die erhöhte Anfälligkeit für schwere Infektionen, insbesondere durch gekapselte Bakterien. Hypersplenismus kann zu Anämie, erhöhter Blutungsneigung und einem höheren Infektionsrisiko führen. Chronische kongestive Splenomegalie kann zu Komplikationen wie portaler Hypertonie und Varizenblutungen führen. Milzabszesse können zu Sepsis oder Milzruptur führen. Große Milzzysten können druckbedingte Beschwerden oder Rupturen verursachen. Ein Milzinfarkt kann zur Bildung von Abszessen und in schweren Fällen zu einer überwältigenden Infektion führen.
Untersuchung und Diagnose
Eine genaue Diagnose von Milzerkrankungen ist für eine wirksame Behandlung unerlässlich. Der Diagnoseprozess umfasst in der Regel eine klinische Untersuchung sowie eine Reihe von Labortests und bildgebenden Untersuchungen.
Klinische Untersuchung:
Eine gründliche Anamnese ist der erste Schritt bei der Diagnose von Milzerkrankungen. Das medizinische Fachpersonal erkundigt sich nach den Symptomen des Patienten, ihrer Dauer und ihrem Verlauf, nach kürzlich erlittenen Traumata oder Infektionen sowie nach relevanten Erkrankungen. Informationen über Medikamente, chirurgische Eingriffe (einschließlich einer möglichen Splenektomie), Milzerkrankungen in der Familienanamnese und Reisen in Gebiete mit einem erhöhten Risiko für bestimmte Infektionen (wie Malaria) sind von entscheidender Bedeutung.
Die anschließende körperliche Untersuchung konzentriert sich auf die Beurteilung der Vitalzeichen, des allgemeinen Erscheinungsbildes und spezifischer Befunde im Zusammenhang mit Milzerkrankungen. Die Ärzte tasten den Bauch ab, um festzustellen, ob die Milz vergrößert ist (Splenomegalie). Bei Verdacht auf Splenomegalie beurteilen sie deren Größe, Beschaffenheit und Druckempfindlichkeit. Durch Abtasten können auch Anzeichen von Bauchschmerzen, Blähungen oder Knoten festgestellt werden. Darüber hinaus suchen Ärzte nach Anzeichen einer Gelbsucht, die auf zugrunde liegende Leber- oder Bluterkrankungen hinweisen kann.
Laboruntersuchungen und Bildgebung:
● Großes Blutbild (CBC): Ein CBC ist eine grundlegende Blutuntersuchung, die wertvolle Informationen über die Anzahl der Blutzellen, einschließlich roter Blutkörperchen, weißer Blutkörperchen und Blutplättchen, liefert. Abweichungen in diesen Werten können auf eine Milzerkrankung hinweisen. Insbesondere eine verminderte Anzahl roter Blutkörperchen (Anämie) oder eine niedrige Thrombozytenzahl kann auf eine Hypersplenismus oder eine chronische kongestive Splenomegalie hindeuten.
● Peripherer Blutausstrich: Eine mikroskopische Untersuchung eines peripheren Blutausstrichs ermöglicht die Beurteilung der Morphologie der Blutzellen. Anomalien im Erscheinungsbild der roten Blutkörperchen, weißen Blutkörperchen oder Thrombozyten können Aufschluss über die zugrunde liegende Ursache der Milzerkrankung geben. Beispielsweise kann das Vorhandensein fragmentierter roter Blutkörperchen (Schistozyten) auf eine hämolytische Anämie hindeuten.
● Leberfunktionstests (LFTs): LFTs können dabei helfen, die Leberfunktion zu beurteilen und Leberanomalien zu erkennen, die mit Milzerkrankungen in Verbindung stehen können. Erhöhte Leberenzym- oder Bilirubinwerte können auf eine Leberstauung oder -funktionsstörung hinweisen.
● Serumchemie: Umfassende Stoffwechseluntersuchungen können Informationen über den Elektrolythaushalt, die Nierenfunktion und Stoffwechselanomalien liefern. Anomalien im Elektrolythaushalt oder in der Nierenfunktion können manchmal in Verbindung mit Milzerkrankungen auftreten.
● Blutkulturen: Blutkulturen sind unerlässlich, wenn eine Infektion als Ursache für eine Milzerkrankung vermutet wird, insbesondere bei Milzabszessen. Die Identifizierung des spezifischen Infektionserregers durch Blutkulturen ist für eine gezielte Antibiotikatherapie von entscheidender Bedeutung.
● Bildgebende Untersuchungen: Bildgebende Untersuchungen wie Ultraschall, CT-Scans oder MRT sind wertvolle Hilfsmittel, um die Milz darzustellen und ihre Größe und Struktur zu beurteilen. Ultraschall wird häufig als erste bildgebende Methode eingesetzt, um Splenomegalie, Zysten oder Abszesse zu beurteilen. CT-Scans oder MRT können für eine detailliertere Beurteilung angeordnet werden, insbesondere wenn zusätzliche Informationen über die umgebenden Strukturen benötigt werden.
● Knochenmarkpunktion und -biopsie: In bestimmten Fällen kann eine Knochenmarkpunktion und -biopsie erforderlich sein, um die Produktion von Blutzellen im Knochenmark zu beurteilen. Dieses Verfahren kann wertvolle Informationen über die zugrunde liegende Ursache der Milzerkrankung liefern, wie z. B. myelodysplastisches Syndrom oder Leukämie.
Die Kombination aus klinischer Untersuchung und Labortests sowie geeigneten bildgebenden Verfahren ermöglicht es den Gesundheitsdienstleistern, die zugrunde liegende Ursache der Milzerkrankung zu bestimmen und geeignete Behandlungs- und Managementstrategien festzulegen.
Therapie und Behandlungen
Milzerkrankungen umfassen eine Reihe von Zuständen, die jeweils spezifische Behandlungsstrategien erfordern, die auf der zugrunde liegenden Ursache und dem Schweregrad der Erkrankung basieren. Die Behandlungsansätze zielen darauf ab, die Symptome zu lindern, die Ursache zu bekämpfen und Komplikationen zu verhindern.
Medikamentöse Behandlung:
● Arzneimittelinduzierte Milzerkrankungen: In Fällen, in denen Milzerkrankungen durch Medikamente verursacht werden, besteht die primäre Maßnahme darin, das verursachende Medikament abzusetzen. Das medizinische Fachpersonal wird die Risiken und Vorteile alternativer Medikamente sorgfältig abwägen und in enger Zusammenarbeit mit den Patienten die am besten geeigneten Behandlungsoptionen ermitteln.
● Infektionen: Milzerkrankungen, die durch Infektionen verursacht werden, wie Milzabszesse oder Milzinfarkte, erfordern eine gezielte Antibiotika- oder Antimykotika-Therapie. Die Wahl der antimikrobiellen Wirkstoffe hängt von dem spezifischen Infektionserreger ab, der durch Blutkulturen oder bildgebende Untersuchungen identifiziert wurde.
Behandlung der Grunderkrankungen:
Bestimmte Milzerkrankungen können sekundär zu Grunderkrankungen wie Lebererkrankungen oder Blutkrankheiten auftreten. Eine wirksame Behandlung dieser Grunderkrankungen ist entscheidend für die Linderung der Symptome und die Vorbeugung wiederkehrender milzbezogener Komplikationen. Dies kann je nach Bedarf Medikamente, Änderungen des Lebensstils oder chirurgische Eingriffe umfassen.
Schmerzbehandlung:
Personen mit Milzerkrankungen können unter Bauchschmerzen, Beschwerden oder Druckempfindlichkeit leiden, insbesondere bei Splenomegalie. Gesundheitsdienstleister können Strategien zur Schmerzbehandlung empfehlen, wie z. B. rezeptfreie Schmerzmittel oder verschreibungspflichtige Medikamente, um diese Symptome zu lindern und die Lebensqualität des Patienten zu verbessern.
Bluttransfusionen:
Bei schwerer Anämie infolge chronischer Milzerkrankungen oder erheblichem Blutverlust können Bluttransfusionen mit gepackten roten Blutkörperchen (PRBCs) erforderlich sein. Diese Maßnahme zielt darauf ab, den Hämoglobinspiegel wieder aufzufüllen und die Sauerstoffversorgung des Gewebes zu unterstützen.
Minimalinvasive Verfahren:
Bestimmte Milzerkrankungen, wie z. B. Milzzysten, erfordern möglicherweise minimalinvasive Verfahren zur Behandlung. Zu diesen Verfahren gehören die perkutane Drainage von Zysten oder die Aspiration und Sklerotherapie, um die Größe der Zysten zu verringern.
Splenektomie:
In schweren oder refraktären Fällen von Milzerkrankungen, insbesondere bei Splenomegalie oder bestimmten hämatologischen Erkrankungen, kann eine chirurgische Entfernung der Milz (Splenektomie) in Betracht gezogen werden. Eine Splenektomie kann zu einer Linderung der Symptome führen und weitere Komplikationen verhindern, birgt jedoch auch langfristige Risiken, wie z. B. eine erhöhte Anfälligkeit für bestimmte Infektionen. Daher wird die Entscheidung für eine Splenektomie sorgfältig gegen die potenziellen Vorteile abgewogen.
Knochenmarktransplantation:
Für Personen mit Milzerkrankungen, die mit zugrunde liegenden Knochenmarkerkrankungen wie myelodysplastischen Syndromen (MDS) oder Leukämie zusammenhängen, kann eine Knochenmarktransplantation eine Behandlungsoption sein. Dieses Verfahren zielt darauf ab, das defekte Knochenmark durch gesunde Stammzellen zu ersetzen, die funktionsfähige Blutzellen produzieren können.
Genetische Beratung:
Bei angeborenen oder genetisch bedingten Milzerkrankungen ist eine genetische Beratung für die Betroffenen und ihre Familien unerlässlich. Diese bietet Informationen über die genetischen Grundlagen der Erkrankung, Vererbungsmuster und Möglichkeiten der Familienplanung.
Es ist wichtig zu betonen, dass die Wahl der Behandlung von Milzerkrankungen sehr individuell ist und von der spezifischen Diagnose, dem allgemeinen Gesundheitszustand des Patienten und dem Vorliegen von Komplikationen abhängt.
Ursachen und Risikofaktoren
Milzerkrankungen umfassen ein Spektrum von Erkrankungen, die jeweils unterschiedliche Ursachen und Risikofaktoren haben. Das Verständnis der zugrunde liegenden Ursachen und die Identifizierung potenzieller Risikofaktoren sind für eine wirksame Prävention und Behandlung unerlässlich.
Ursachen:
Milzerkrankungen umfassen eine Vielzahl von Erkrankungen, die jeweils unterschiedliche Ursachen haben. Diese Erkrankungen können auf verschiedene Faktoren zurückgeführt werden, darunter Infektionen, Blutkrankheiten, Entzündungen, Traumata, Medikamente und genetische Faktoren. Infektionen, wie bakterielle oder Pilzinfektionen, können die Milz direkt befallen und zu Erkrankungen wie Milzabszessen führen. Hämatologische Erkrankungen wie myelodysplastische Syndrome und Leukämie können die normale Produktion von Blutzellen stören und möglicherweise die Funktion der Milz beeinträchtigen. Chronische Entzündungskrankheiten wie Autoimmunerkrankungen können Immunreaktionen hervorrufen, die fälschlicherweise das Milzgewebe angreifen und schädigen, was zu Erkrankungen wie Splenomegalie oder Hypersplenismus führt.
Ein physisches Trauma des Abdomens kann zu Milzverletzungen wie Rupturen oder Hämatomen führen, die die Struktur und Funktion der Milz erheblich beeinträchtigen können. Darüber hinaus können bestimmte Medikamente, insbesondere Immunsuppressiva und Antikoagulanzien, Nebenwirkungen haben, die die Milzfunktion beeinflussen oder das Risiko für milzbezogene Komplikationen erhöhen. Auch genetische Veranlagung kann bei einigen Milzerkrankungen eine Rolle spielen, wobei bestimmte genetische Mutationen zu Erkrankungen wie der hereditären Sphärozytose beitragen, bei der abnormale rote Blutkörperchen dazu neigen, in der Milz eingeschlossen und zerstört zu werden. Diese vielfältigen Ursachen unterstreichen die Bedeutung einer umfassenden Untersuchung und maßgeschneiderter Behandlungsstrategien für Menschen, die von Milzerkrankungen betroffen sind.
Risikofaktoren:
Obwohl die genauen Ursachen für Milzerkrankungen variieren können, gibt es mehrere Risikofaktoren, die mit einer erhöhten Wahrscheinlichkeit für das Auftreten dieser Erkrankungen verbunden sind. Zu den Risikofaktoren gehören:
● Alter: Das Alter kann ein Einflussfaktor sein, da bestimmte Milzerkrankungen, wie z. B. Splenomegalie, mit zunehmendem Alter häufiger auftreten können. Darüber hinaus haben ältere Menschen möglicherweise ein höheres Risiko für Komplikationen im Zusammenhang mit Milzerkrankungen.
● Grunderkrankungen: Personen mit Vorerkrankungen, insbesondere Autoimmunerkrankungen wie Lupus oder rheumatoide Arthritis, haben ein erhöhtes Risiko, Milzerkrankungen zu entwickeln, da die Immunreaktionen des Körpers auf das Milzgewebe abzielen.
● Medikamenteneinnahme: Wie bereits erwähnt, können bestimmte Medikamente mit Milzerkrankungen in Verbindung gebracht werden. Patienten, die Immunsuppressiva oder Antikoagulanzien einnehmen, haben möglicherweise ein erhöhtes Risiko.
● Genetische Veranlagung: Bei angeborenen oder genetisch bedingten Milzerkrankungen kann eine familiäre Vorbelastung das Risiko für Nachkommen erhöhen. Bestimmte genetische Mutationen können Personen für diese Erkrankungen prädisponieren.
● Trauma oder Verletzung: Die Ausübung von Aktivitäten oder Berufen mit einem höheren Risiko für Bauchtraumata kann die Wahrscheinlichkeit von Milzverletzungen erhöhen, die zu Milzerkrankungen führen können.
Es ist wichtig zu beachten, dass das Vorliegen dieser Risikofaktoren nicht garantiert, dass eine Milzerkrankung auftritt, und viele Personen mit diesen Risikofaktoren entwickeln möglicherweise nie solche Erkrankungen. Umgekehrt können Milzerkrankungen auch bei Personen ohne erkennbare Risikofaktoren auftreten.
Verlauf der Erkrankung und Prognose
Das Verständnis des typischen Verlaufs von Milzerkrankungen und ihrer Prognose ist sowohl für medizinisches Fachpersonal als auch für Patienten von entscheidender Bedeutung. Milzerkrankungen umfassen eine Vielzahl von Erkrankungen, und obwohl jede Erkrankung ihre eigenen Merkmale aufweist, gibt es Gemeinsamkeiten im Verlauf dieser Erkrankungen.
Verlauf der Erkrankung:
Die Entwicklung von Milzerkrankungen folgt oft einem Muster, das sich in mehrere Stadien unterteilen lässt, wobei der genaue Zeitverlauf und der Schweregrad je nach Grunderkrankung variieren können. Diese Stadien geben einen allgemeinen Überblick über den Krankheitsverlauf:
● Asymptomatisches Stadium: In vielen Fällen beginnen Milzerkrankungen unbemerkt, mit wenigen bis gar keinen erkennbaren Symptomen. In diesem Stadium sind sich die Patienten möglicherweise nicht bewusst, dass die Erkrankung fortschreitet. Bei einigen Personen können leichte Beschwerden oder ein Völlegefühl im linken Oberbauch auftreten, aber diese Symptome werden oft ignoriert oder anderen Ursachen zugeschrieben.
● Symptomatisches Stadium: Mit fortschreitender Erkrankung werden die Symptome deutlicher und störender. Zu den häufigsten Symptomen von Milzerkrankungen gehören Bauchschmerzen oder -beschwerden, insbesondere im linken Oberbauch, die bis in die linke Schulter ausstrahlen können. Patienten bemerken möglicherweise auch eine frühe Sättigung, d. h. sie fühlen sich schon nach dem Verzehr einer kleinen Mahlzeit satt. In diesem Stadium können auch Müdigkeit, unerklärlicher Gewichtsverlust und Anämie (Mangel an roten Blutkörperchen) auftreten.
● Komplikationen: Unbehandelt oder nicht kontrolliert können Milzerkrankungen zu Komplikationen führen. Dazu kann Hypersplenismus gehören, ein Zustand, bei dem die Milz überaktiv wird und Blutzellen vorzeitig zerstört, was zu Anämie, Thrombozytopenie (niedrige Thrombozytenzahl) und Leukopenie (niedrige Anzahl weißer Blutkörperchen) führt. Eine weitere mögliche Komplikation ist die Bildung von Abszessen in der Milz, die starke Schmerzen, Fieber und sogar Sepsis verursachen können.
● Fortgeschrittene Erkrankung: Wenn Milzerkrankungen ungehindert fortschreiten, können sie zu fortgeschrittenen Stadien führen. Dies geht oft mit einer deutlichen Vergrößerung der Milz (Splenomegalie) einher, was zu schwereren Symptomen und weiteren Komplikationen führen kann. In bestimmten Situationen, wie z. B. bei Milztumoren, kann sich die Erkrankung auf benachbarte Gewebe oder Organe ausbreiten.
Prognose:
Die Prognose für Menschen mit Milzerkrankungen ist unterschiedlich und wird von mehreren Faktoren beeinflusst. Die spezifische Art der Milzerkrankung ist ein entscheidender Faktor für die Prognose. Einige Erkrankungen, wie z. B. eine durch eine Infektion verursachte Splenomegalie, können bei rechtzeitiger Diagnose und wirksamer Behandlung eine günstige Prognose haben. Andere, wie bestimmte Krebsarten der Milz, können eine schwierigere Prognose haben.
Eine frühzeitige Diagnose und Intervention spielen eine entscheidende Rolle bei der Verbesserung der Prognose von Milzerkrankungen. Die rechtzeitige Identifizierung und Behandlung der zugrunde liegenden Ursache kann Komplikationen verhindern und die langfristigen Ergebnisse verbessern. Erfolgreiche Behandlungsmaßnahmen, einschließlich Medikamenten, Therapien oder Operationen, können die Prognose erheblich beeinflussen. Patienten, die gut auf die Behandlung ansprechen und eine Linderung der Symptome erfahren, haben in der Regel eine positivere Prognose.
Personen mit Grunderkrankungen oder einem geschwächten Immunsystem können bei der Behandlung von Milzerkrankungen mit zusätzlichen Herausforderungen konfrontiert sein, die sich möglicherweise auf ihre Prognose auswirken. Das Auftreten von Komplikationen wie Abszessen oder schwerem Hypersplenismus kann die Prognose verschlechtern. Die rechtzeitige Erkennung und Behandlung dieser Komplikationen ist entscheidend, um ihre Auswirkungen zu mildern.
Die Einhaltung der Behandlungspläne und medizinischen Empfehlungen durch den Patienten ist ein weiterer entscheidender Faktor für die Prognose. Die Einnahme der verschriebenen Medikamente, Änderungen des Lebensstils und regelmäßige Nachsorgetermine sind für den langfristigen Erfolg unerlässlich.
Prävention
Die Vorbeugung von Milzerkrankungen oder die Verringerung des Risikos ihres Auftretens ist ein wichtiger Aspekt für die Erhaltung der allgemeinen Gesundheit. Zwar sind nicht alle Milzerkrankungen vollständig vermeidbar, doch können verschiedene Strategien und Maßnahmen dazu beitragen, das Risiko für die Entwicklung dieser Erkrankungen oder das Auftreten von Komplikationen zu verringern.
Impfungen:
Impfungen spielen eine entscheidende Rolle bei der Vorbeugung bestimmter Infektionen, die zu Milzerkrankungen führen können. Impfstoffe gegen Krankheiten wie Influenza, Lungenentzündung und Haemophilus influenzae Typ b (Hib) sind besonders wichtig für Risikopersonen. Diese Impfstoffe tragen dazu bei, die Wahrscheinlichkeit von Infektionen zu verringern, die die Milz beeinträchtigen können.
Hygiene und Infektionskontrolle:
Gute Hygiene und Infektionskontrollmaßnahmen können das Risiko von Infektionen, die zu Milzerkrankungen wie Milzabszessen führen können, erheblich verringern. Dazu gehören gründliches Händewaschen, die Vermeidung von engem Kontakt mit Personen, die an ansteckenden Krankheiten leiden, und die richtige Wundversorgung, um bakterielle Infektionen zu verhindern.
Vermeidung riskanter Verhaltensweisen:
Risikoreiches Verhalten, wie z. B. intravenöser Drogenkonsum, kann das Risiko für Infektionen wie Endokarditis erhöhen, die die Milz betreffen können. Die Vermeidung solcher Verhaltensweisen ist für die Prävention unerlässlich.
Behandlung von Grunderkrankungen:
Für Personen mit Grunderkrankungen, die sie für Milzerkrankungen prädisponieren, ist eine angemessene Behandlung der Erkrankung von entscheidender Bedeutung. Dies kann die Behandlung chronischer Infektionen, Autoimmunerkrankungen oder Blutkrankheiten durch Medikamente, Änderungen des Lebensstils und regelmäßige medizinische Überwachung umfassen.
Vorsichtsmaßnahmen auf Reisen:
Bei Reisen in Regionen, in denen bestimmte Infektionen wie Malaria verbreitet sind, ist es wichtig, geeignete Vorsichtsmaßnahmen zu treffen. Dazu gehören die Einnahme von Malariamedikamenten, die Verwendung von Insektenschutzmitteln und das Schlafen unter Moskitonetzen. Die Vorbeugung von Malaria kann dazu beitragen, die Milz vor möglichen Schäden durch die Krankheit zu schützen.
Sicherheitsmaßnahmen:
Um Verletzungen der Milz zu vermeiden, ist es wichtig, Aktivitäten auszuüben, die das Risiko von körperlichen Traumata im Bauchraum verringern. Dazu gehören das Anlegen von Sicherheitsgurten in Fahrzeugen und die Ausübung von Sportarten mit geeigneter Sicherheitsausrüstung und unter Einhaltung der Regeln.
Ernährung und Ernährung:
Eine gesunde Ernährung und Lebensweise kann die allgemeine Gesundheit des Immunsystems unterstützen. Eine ausgewogene Ernährung mit viel Obst, Gemüse und magerem Eiweiß, eine ausreichende Flüssigkeitszufuhr und regelmäßige Bewegung können zum allgemeinen Wohlbefinden beitragen und indirekt zur Vorbeugung von Milzerkrankungen beitragen.
Regelmäßige ärztliche Untersuchungen:
Regelmäßige Vorsorgeuntersuchungen sind für die Früherkennung und Behandlung von Grunderkrankungen, die das Risiko für Milzerkrankungen erhöhen können, unerlässlich. Regelmäßige Vorsorgeuntersuchungen können auch dazu beitragen, die Gesundheit der Milz selbst zu überwachen und bei Feststellung von Anomalien frühzeitig einzugreifen.
Aufklärung und Information:
Die Aufklärung von sich selbst und anderen über die Risikofaktoren für Milzerkrankungen, insbesondere für Personen mit genetischer Veranlagung oder bestimmten Erkrankungen, kann zu einer früheren Erkennung und rechtzeitigen Präventionsmaßnahmen führen.
Es ist wichtig zu beachten, dass die Wirksamkeit von Präventionsstrategien je nach individuellen Faktoren und der jeweiligen Milzerkrankung variieren kann.
Zusammenfassung
Milzerkrankungen umfassen eine Reihe von Erkrankungen, die die Milz betreffen, ein wichtiges Organ im linken Oberbauch. Diese Erkrankungen variieren in ihren Symptomen und ihrem Schweregrad und umfassen Hyposplenismus, Hypersplenismus, Splenomegalie, Milzabszesse, Milzzysten und Milzinfarkte. Die frühen Stadien sind oft asymptomatisch und entwickeln sich zu Symptomen wie Bauchschmerzen, frühzeitiger Sättigung und Müdigkeit. Unbehandelt können Komplikationen auftreten, darunter schwere Infektionen, Anämie und Milzvergrößerung. Die Diagnose umfasst eine klinische Untersuchung, Labortests und bildgebende Verfahren. Die Behandlung hängt von der zugrunde liegenden Ursache ab und kann die Absetzung von Medikamenten, die Behandlung von Infektionen, Schmerzlinderung, Bluttransfusionen, minimalinvasive Eingriffe, Splenektomie oder Knochenmarktransplantation umfassen. Zu den Präventionsstrategien gehören Impfungen, Hygiene, die Vermeidung riskanter Verhaltensweisen, die Behandlung von Grunderkrankungen, Vorsichtsmaßnahmen auf Reisen, Sicherheitsmaßnahmen, die Aufrechterhaltung eines gesunden Lebensstils, regelmäßige Vorsorgeuntersuchungen und die Sensibilisierung der Bevölkerung. Die Einhaltung medizinischer Empfehlungen und rechtzeitige Interventionen sind entscheidend für eine Verbesserung der Prognose.